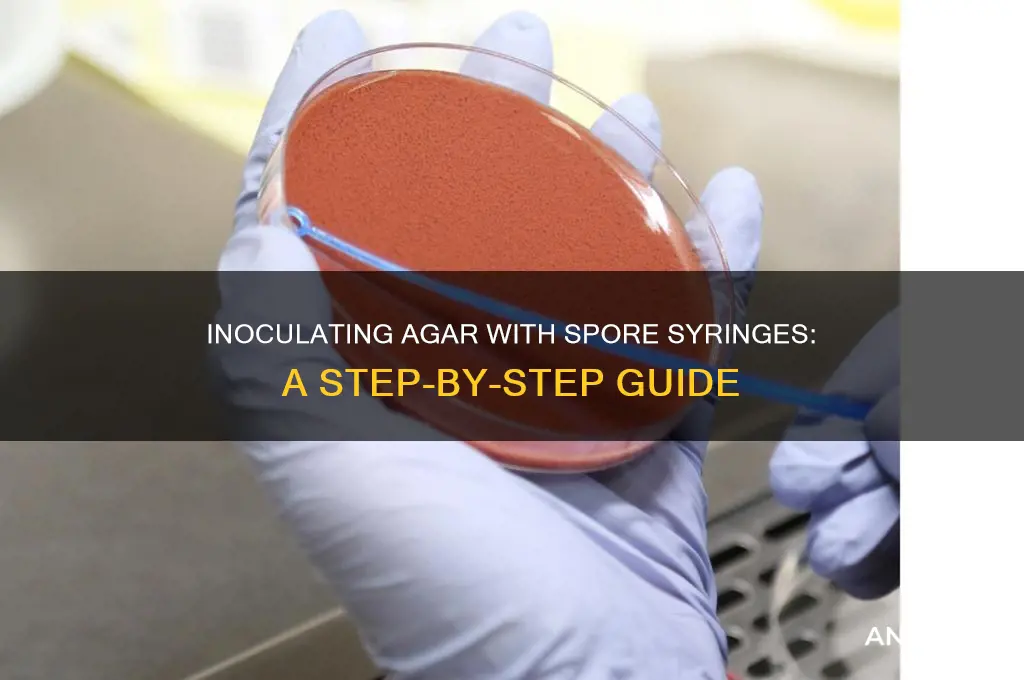
can you inoculate agar with spore syringe

Inoculating agar with a spore syringe is a common technique in mycology and microbiology, used to cultivate fungi or bacteria on a nutrient-rich medium. This process involves carefully transferring spores from the syringe onto the surface of the agar, providing a controlled environment for growth and observation. While spore syringes are typically associated with mushroom cultivation, they can also be utilized for various scientific and research purposes. The success of inoculation depends on factors such as sterility, proper technique, and the viability of the spores, making it a precise and delicate procedure. Understanding the steps and best practices for this method is essential for anyone looking to study or cultivate microorganisms effectively.
| Characteristics | Values |
|---|---|
| Method Feasibility | Yes, it is possible to inoculate agar with a spore syringe. |
| Purpose | To cultivate mushrooms by transferring mycelium from spores to a nutrient-rich agar medium. |
| Agar Type | Typically Potato Dextrose Agar (PDA) or Malt Extract Agar (MEA), sterilized and cooled. |
| Sterilization Requirement | Agar must be sterilized (autoclave or pressure cooker) to prevent contamination. |
| Inoculation Process | Inject a small amount of spore solution from the syringe into the agar surface or well. |
| Contamination Risk | High if proper sterile technique is not followed (e.g., flame sterilization of syringe needle). |
| Incubation Conditions | Incubate at 22-28°C (72-82°F) in a dark, sterile environment for 7-14 days. |
| Expected Outcome | Mycelial growth should appear as white, thread-like structures spreading across the agar. |
| Common Issues | Contamination by bacteria, mold, or other fungi if sterilization is inadequate. |
| Alternative Methods | Using spore prints or tissue culture instead of spore syringes for inoculation. |
| Success Rate | Varies based on spore viability, sterilization, and technique; typically 70-90% with proper execution. |
| Applications | Used in mycology, mushroom cultivation, and research to isolate and grow fungal cultures. |
Explore related products
$6.99
What You'll Learn

Sterilization Techniques for Agar Plates
Agar plates are a cornerstone of microbiology, providing a solid medium for cultivating microorganisms. However, their effectiveness hinges on one critical step: sterilization. Contamination can render results meaningless, making proper sterilization techniques essential.
Here, we delve into the specific methods and considerations for sterilizing agar plates, particularly when inoculating with spore syringes.
Autoclaving: The Gold Standard
Autoclaving reigns supreme as the most reliable sterilization method for agar plates. This process utilizes saturated steam under pressure (typically 121°C and 15 psi) for 15-20 minutes. The intense heat and pressure effectively kill all microorganisms, including spores. Ensure your autoclave reaches and maintains these parameters for the designated time. After autoclaving, allow the agar to cool to around 50-50°C before pouring into petri dishes. This prevents the agar from solidifying too quickly and ensures even distribution.
Surface Sterilization: A Necessary Complement
While autoclaving sterilizes the agar itself, the surface of the agar plate remains vulnerable to contamination during inoculation. Flame sterilization of the spore syringe needle is crucial. Hold the needle in a bunsen burner flame until it glows red, then allow it to cool slightly before piercing the agar. This minimizes the risk of introducing contaminants from the syringe.
Aseptic Technique: The Human Factor
Even with proper autoclaving and surface sterilization, human error can introduce contamination. Adherence to aseptic technique is paramount. Work in a sterile environment, such as a laminar flow hood, to minimize airborne contaminants. Wear sterile gloves and a lab coat, and avoid touching the agar surface or the interior of the petri dish.
Troubleshooting and Considerations
Despite meticulous sterilization, contamination can still occur. If contamination is suspected, examine the plates for unusual growth patterns or colors. Common contaminants include mold, yeast, and bacteria. If contamination is confirmed, discard the plates and repeat the process, carefully reviewing your sterilization procedures. Remember, successful inoculation with spore syringes relies on a combination of effective sterilization techniques and strict adherence to aseptic practices.
Mastering Mushroom Cultivation: Growing Spores from Syringe Step-by-Step
You may want to see also

Proper Syringe Handling and Injection Methods
Inoculating agar with a spore syringe requires precision and care to ensure successful growth and prevent contamination. Proper syringe handling and injection methods are critical to achieving consistent results, whether you’re cultivating mushrooms or working with microbial cultures. The syringe acts as a delicate tool, delivering spores into the agar medium, and mishandling can compromise the entire process. Understanding the mechanics of this step is the first line of defense against failure.
Begin by sterilizing the syringe and needle to eliminate any contaminants. Use a flame from a lighter or alcohol burner to heat the needle until it glows red, then allow it to cool before use. This step ensures the injection site on the agar remains sterile. When drawing the spore solution into the syringe, expel any air bubbles by gently tapping the barrel and depressing the plunger. Air pockets can disrupt the injection process, leading to uneven distribution or wasted spores. Aim for a consistent volume—typically 0.1 to 0.5 mL—depending on the agar plate size and desired colony density.
The injection technique itself demands a steady hand and attention to detail. Insert the needle through the agar surface at a 45-degree angle, ensuring it penetrates no more than halfway through the medium. Slowly depress the plunger to release the spore solution, creating a small, visible droplet beneath the surface. Withdraw the needle swiftly but smoothly to minimize agar damage. Over-insertion or rough handling can cause the agar to crack or become contaminated, rendering the plate unusable. Practice makes perfect; consistency in depth and pressure is key.
Caution must be exercised to avoid common pitfalls. Never reuse a syringe or needle without re-sterilization, as this introduces risks of cross-contamination. If the agar appears dry or brittle, it may not seal properly after injection, leaving it vulnerable to airborne contaminants. Always work in a clean environment, ideally a still air box or laminar flow hood, to minimize exposure to external particles. After injection, seal the plate with parafilm or surgical tape to maintain sterility during incubation.
In conclusion, mastering syringe handling and injection methods transforms inoculation from a gamble into a controlled, repeatable process. By adhering to sterile techniques, precise measurements, and careful execution, you maximize the chances of successful agar colonization. This attention to detail not only ensures reliable results but also fosters a deeper understanding of the cultivation process, making it a cornerstone skill for any practitioner.
Are All Purple Spore Prints Reliable? Unveiling the Truth
You may want to see also

Optimal Agar Preparation and Cooling Process
Agar preparation is a critical step in successful inoculation with a spore syringe, as it directly influences the growth and viability of mycelium. The process begins with selecting the right type of agar—typically potato dextrose agar (PDA) or malt extract agar (MEA)—which provides essential nutrients for fungal growth. Sterilization is paramount; autoclaving the agar mixture at 121°C (250°F) for 15–20 minutes ensures all contaminants are eliminated. Overcooking or undercooking can alter the agar’s consistency, so precise timing is essential. Once sterilized, the agar must cool to a temperature safe for inoculation, typically around 50–60°C (122–140°F), to prevent killing the spores.
Cooling the agar properly is as crucial as sterilization, as it determines the success of the inoculation process. After autoclaving, allow the agar to cool naturally in a sterile environment, avoiding drafts or contaminants. Pouring the agar into Petri dishes or jars should occur when it reaches a gel-like consistency but is still pourable. A common mistake is pouring agar too hot, which can create uneven surfaces or damage the dish. For optimal results, pre-warm the Petri dishes or jars to minimize temperature shock and ensure a smooth, even agar surface. This step is particularly important when working with delicate spore syringes, as inconsistencies can hinder spore germination.
The inoculation process itself requires precision and sterility. Once the agar has cooled to the appropriate temperature, use a sterile technique to introduce the spore syringe. Flame-sterilize the syringe needle and insert it just below the agar’s surface, dispensing a small droplet of spore solution. Over-inoculation can lead to overcrowding, while too little may result in slow or uneven growth. After inoculation, seal the dishes or jars with sterile tape or parafilm to prevent contamination. Incubate in a dark, temperature-controlled environment (22–26°C or 72–78°F) for 7–14 days, monitoring for mycelial growth.
Comparing agar preparation methods reveals that patience and attention to detail yield the best results. Rushing the cooling process or skipping sterilization steps often leads to contamination or failed inoculation. For instance, using a laminar flow hood during agar pouring and inoculation significantly reduces airborne contaminants, though it’s not always necessary for hobbyists. Additionally, experimenting with agar recipes—such as adding activated carbon to reduce impurities—can enhance mycelial growth. Ultimately, the optimal agar preparation and cooling process combines scientific precision with practical techniques, ensuring a sterile, nutrient-rich environment for spore germination.
Can Corynebacterium Form Spores? Unraveling the Bacterial Survival Mystery
You may want to see also
Explore related products

Preventing Contamination During Inoculation Steps
Inoculating agar with a spore syringe is a delicate process where a single misstep can introduce contaminants, jeopardizing the entire culture. The first line of defense is sterilization. Autoclave all equipment—Petri dishes, agar, and inoculation tools—at 121°C for 15–20 minutes to ensure all microorganisms are eradicated. Even the spore syringe should be flame-sterilized by passing the needle through a Bunsen burner flame until it glows red, cooling it before use to avoid killing the spores. This meticulous approach eliminates external contaminants before the inoculation even begins.
The environment in which inoculation occurs is equally critical. Work within a laminar flow hood to create a sterile airflow that displaces particulate matter. If a hood is unavailable, a still-air box or clean, draft-free area can suffice, but the risk of contamination increases. Wipe down surfaces with 70% isopropyl alcohol and allow them to dry completely. Wear sterile gloves and a lab coat, and minimize movement to reduce airborne particles. Even small dust particles can carry contaminants, so treat the workspace as a high-stakes zone where every detail matters.
During inoculation, technique is paramount. Flame the neck of the spore syringe before and after withdrawing the plunger to prevent airborne contaminants from entering. Insert the needle through the agar surface at a shallow angle, depositing a small droplet of spore solution just beneath the surface. Avoid puncturing the agar deeply, as this can create channels for contaminants to enter. After inoculation, flame the needle again and promptly seal the Petri dish with parafilm or surgical tape to maintain sterility. Precision and speed are key to minimizing exposure to the environment.
Post-inoculation, monitor the culture closely for signs of contamination. Incubate the plates at the optimal temperature for your organism, typically 25–30°C for fungi. Inspect daily for unusual growth patterns, discoloration, or off-odors, which indicate contamination. If contamination occurs, discard the plate immediately to prevent cross-contamination. Successful inoculation relies not only on preventing contamination during the process but also on vigilant observation afterward to ensure the culture remains pure.
Does Sterilization Kill Spores? Unraveling the Science Behind Effective Disinfection
You may want to see also

Ideal Incubation Conditions for Spore Growth
Inoculating agar with a spore syringe is a precise process, and achieving optimal spore growth hinges on creating the ideal incubation environment. Temperature is paramount; most spores thrive between 22°C and 28°C (72°F–82°F). Deviations outside this range can stunt growth or promote contamination. For instance, temperatures below 20°C slow metabolic activity, while those above 30°C may denature enzymes essential for spore germination. Consistency is key—fluctuations can disrupt the delicate balance required for successful colonization.
Humidity plays a secondary but crucial role. Spores require moisture to activate and germinate, but excessive dampness invites mold and bacteria. Aim for a relative humidity of 60–70% within the incubation chamber. This can be achieved by placing a shallow tray of water or using a humidifier. However, avoid direct contact between the agar and water sources, as this risks dilution or contamination. Regularly monitor humidity levels with a hygrometer to maintain optimal conditions.
Light exposure is another factor often overlooked. Spores generally prefer darkness for germination, as light can inhibit growth or trigger premature fruiting. Store inoculated agar plates in a dark environment, such as a closed container or a dedicated incubation chamber. If light is unavoidable, use opaque containers or wrap plates in aluminum foil to shield them. This simple step can significantly enhance colonization rates and reduce the risk of failed inoculations.
Airflow is a delicate balance. While spores need oxygen for metabolic processes, excessive air movement can dry out the agar or introduce contaminants. Ensure the incubation area is well-ventilated but not drafty. A small fan on low speed or passive airflow through a slightly open lid can suffice. For sterile environments, consider using a HEPA filter to minimize airborne particles. Proper airflow management prevents stagnation while safeguarding the agar from external threats.
Finally, patience is essential. Spore germination is not instantaneous; it typically takes 7–14 days for visible colonization to occur. Resist the urge to disturb the agar during this period, as handling can introduce contaminants or disrupt growth. Regularly inspect the plates for signs of contamination, such as unusual colors or odors, but do so minimally and under sterile conditions. With the right conditions—temperature, humidity, darkness, and controlled airflow—spore growth on agar becomes a reliable and rewarding process.
Copying Creations in Spore: Tips and Tricks for Duplicating Pieces
You may want to see also
Frequently asked questions
Yes, you can directly inoculate agar with a spore syringe by injecting a small amount of spore solution onto the agar surface, ensuring it is sterile to prevent contamination.
Use 1-2 drops of spore solution from the syringe, as a small amount is sufficient for successful colonization without overcrowding the agar.
Yes, flame-sterilize the needle of the spore syringe with a lighter or alcohol lamp before and after inoculation to maintain sterility and prevent contamination.
Colonization time varies by species, but typically, visible growth appears within 5-14 days under optimal conditions (e.g., proper temperature and humidity).
Yes, you can reuse a spore syringe if it remains sterile. Flame-sterilize the needle between uses and store the syringe properly to avoid contamination.

























